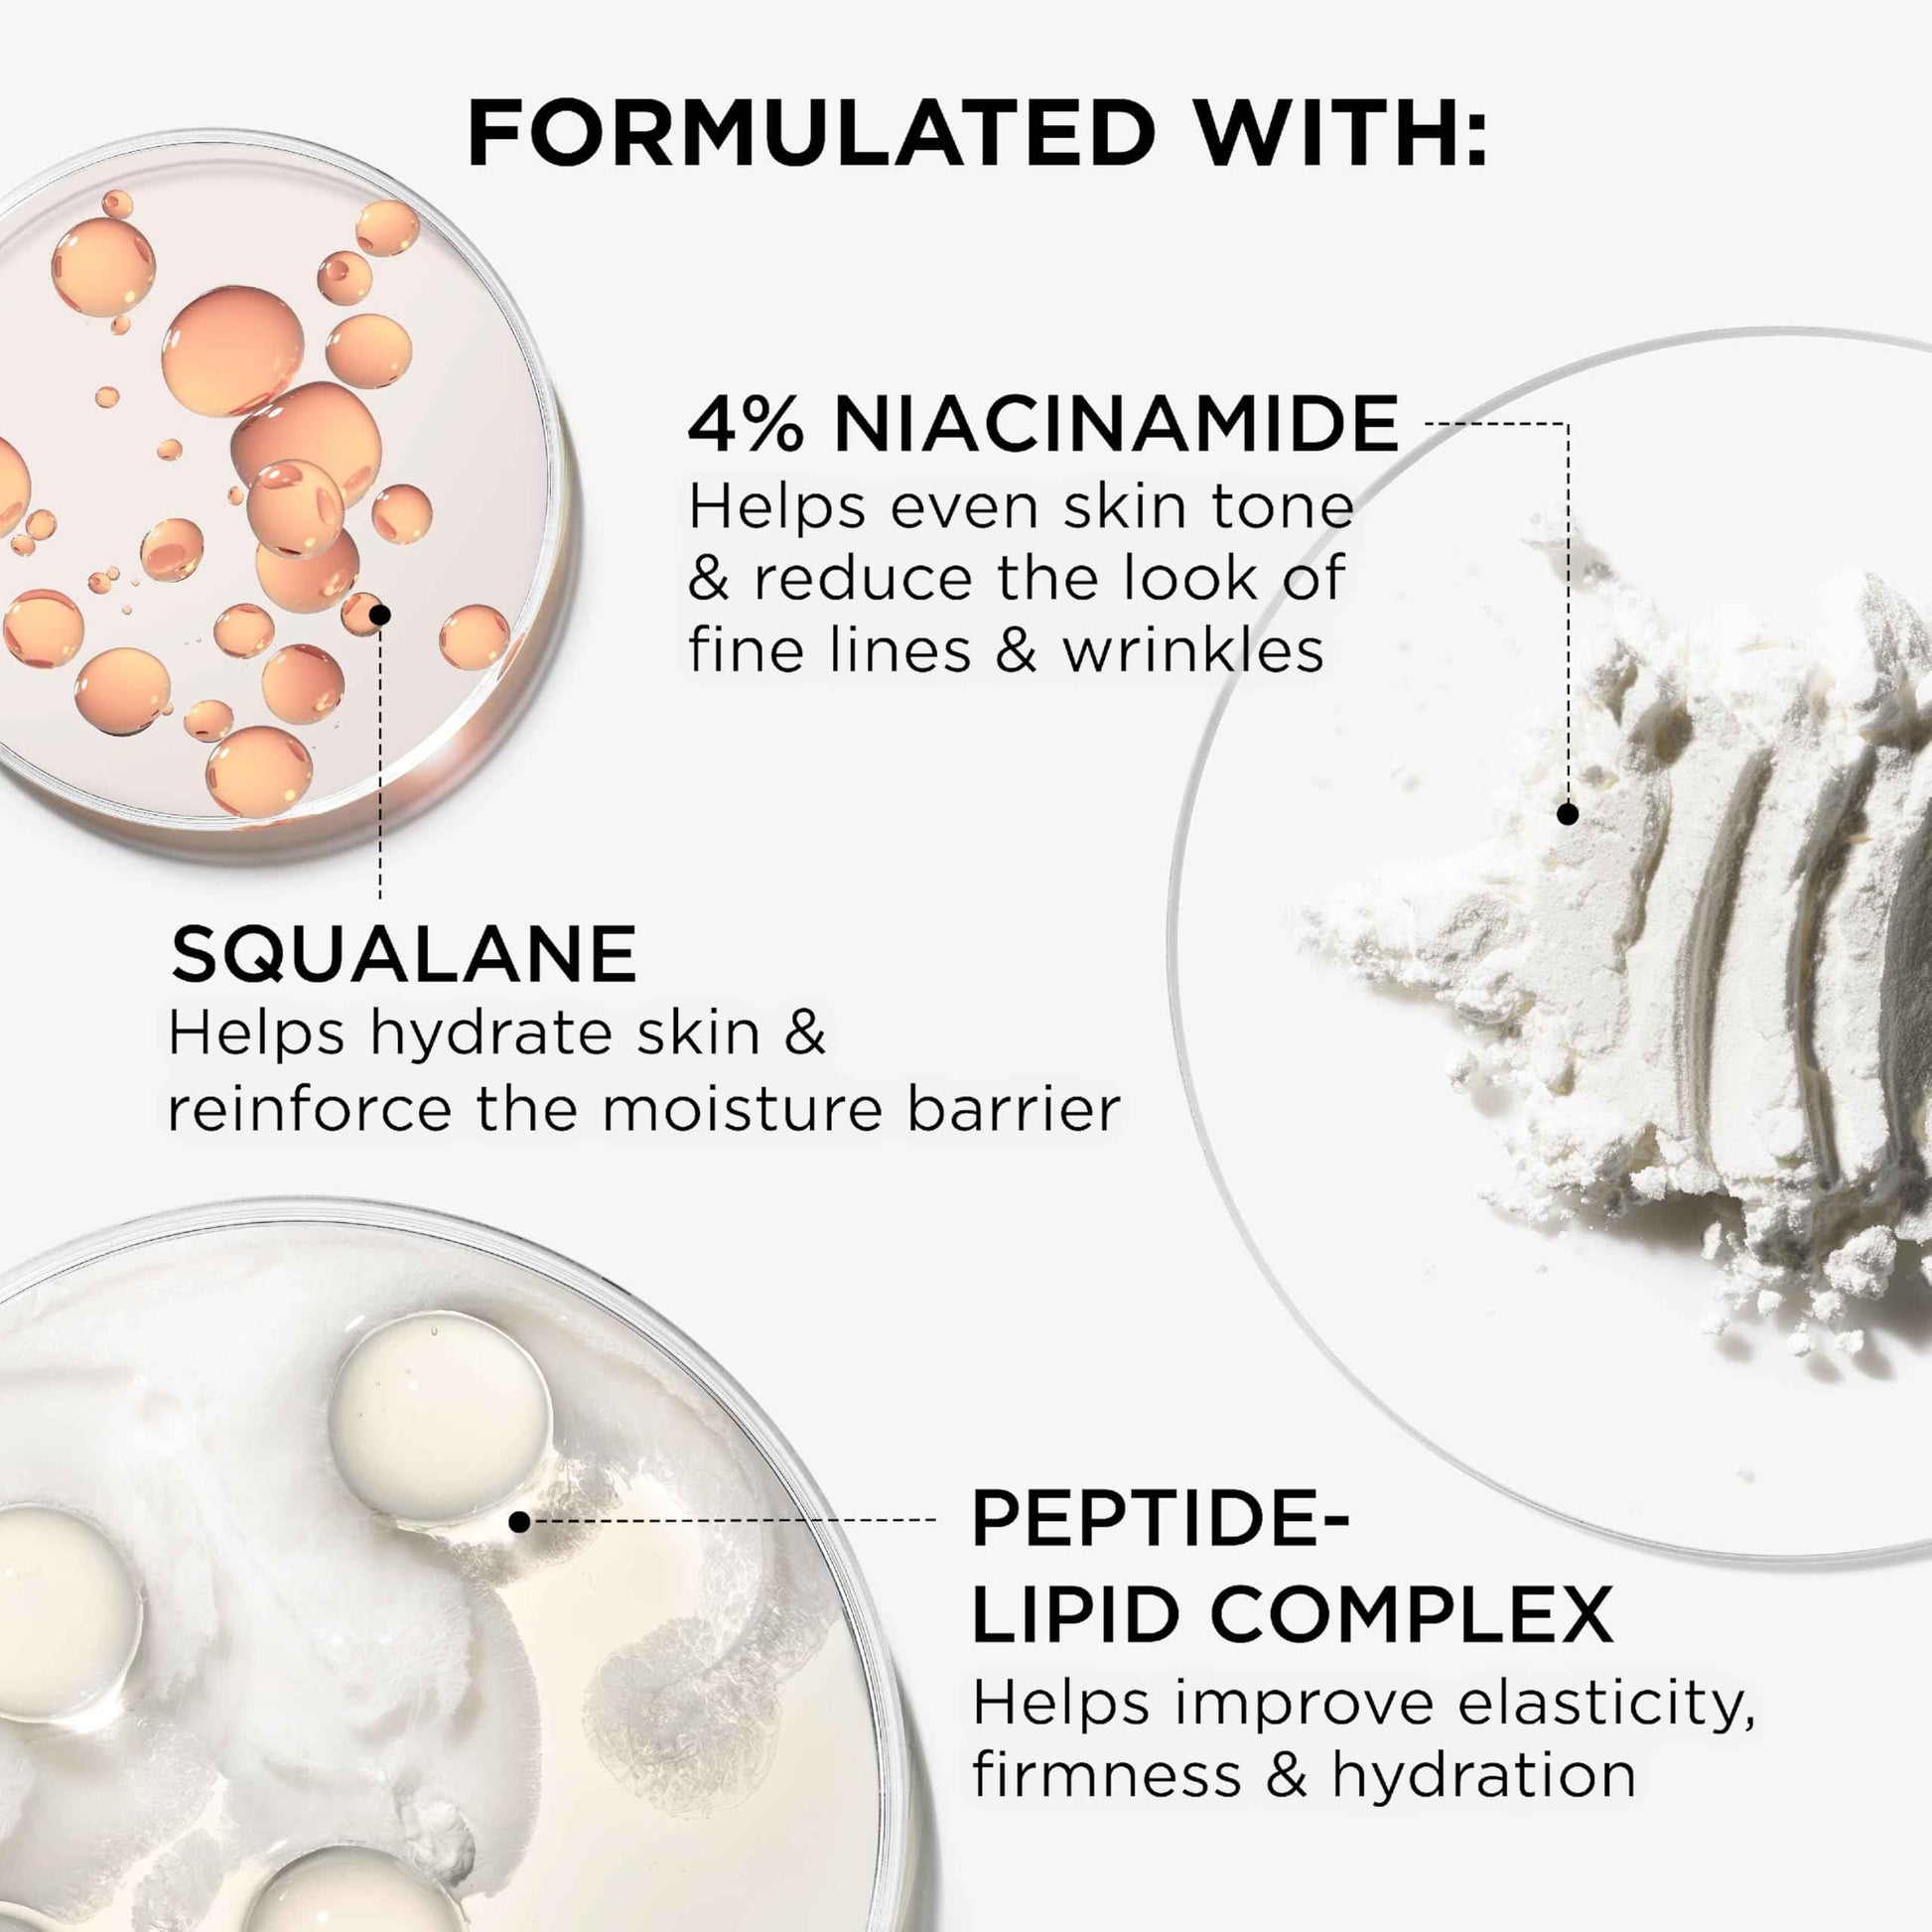

1
/
of
10
IT Cosmetics
IT Cosmetics Confidence in a Cream Travel - Hydrating & Anti Aging Face Moisturizer, Visibly Reduces Fine Lines & Wrinkles, Up To 48H Hydration, Repairs Skin Barrier, Squalane & Ceramides - 0.5 fl oz
IT Cosmetics Confidence in a Cream Travel - Hydrating & Anti Aging Face Moisturizer, Visibly Reduces Fine Lines & Wrinkles, Up To 48H Hydration, Repairs Skin Barrier, Squalane & Ceramides - 0.5 fl oz
Regular price
$32.95 USD
Regular price
$65.99 USD
Sale price
$32.95 USD
Unit price
/
per
Tax included.
Shipping calculated at checkout.
Couldn't load pickup availability
Brand: IT Cosmetics
Color: Clear
Features:
- WHY YOU’LL LOVE IT - From the #1 women’s anti-aging moisturizer franchise, this all-in-one face cream repairs the skin barrier and reverses signs of aging. Its rich texture absorbs quickly for instant hydration and radiant, youthful-looking skin
- IT REALLY WORKS - With patented concentrate featuring niacinamide and peptide lipid complex, it reverses major aging signs in 2 weeks: fine lines, dullness, dryness, wrinkles, firmness, elasticity, pores, texture, and uneven skin tone
- INGREDIENTS - Formulated with niacinamide to even skin tone and reduce fine lines/wrinkles; peptide-lipid complex to boost elasticity and firmness; squalane to hydrate and strengthen the moisture barrier for healthier skin
- BENEFITS FOR EVERYONE - Dermatologist-recommended, vegan formula, tested on all skin types and diverse skin tones. Strengthens skin’s moisture barrier in 1 hour with hydration lasting up to 48 hours for lasting skin rejuvenation
- HOW TO APPLY - Apply to clean skin morning and evening. Use a quarter-size amount on areas needing moisture and rejuvenation. Provides quick hydration and serves as an primed base for makeup application, such as CC+ cream foundation with spf 50
Binding: Health and Beauty
Part Number: S5066300
EAN: 3605972780119
Package Dimensions: 1.5 x 1.4 x 1.3 inches
Share